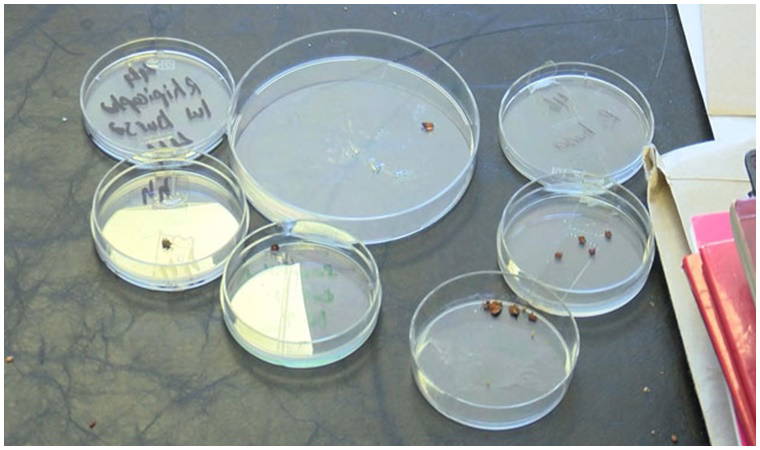

Koronavirüs salgını nedeniyle vatandaşlar arazi ve ormanlık alanları boş bıraktı, hava sıcaklıklarının yükselmesiyle birlikte kene vakaları arttı. Uzmanlar, İstanbul’daki kene türlerinin ölümcül bir hastalığa neden olmadığını ifade etse de vatandaşları, arazilerde ve ormanlık alanlarda dikkatli olmaları gerektiği konusunda uyarıyor. Koronavirüs salgınındaki yasaklar nedeniyle insanların doğayı bozamadıkları, üreme alanlarına kimse dokunmadığı için de kenelerin çoğaldığı bildiriliyor.
İstanbul’daki kene türlerinin ölümcül bir hastalık olan Kırım Kongo Kanamalı Ateşine neden olmadığını ifade eden İstanbul Üniversitesi Cerrahpaşa-Cerrahpaşa Tıp Fakültesi Tıbbi Parazitoloji Bilim Dalı Öğretim Üyesi Doç. Dr. Erdal Polat, bir başka ciddi hastalık olan ‘Lyme’a karşı uyarılarda bulundu. Doç. Dr. Polat, “Keneyi çıkardıktan sonra türlerine bakıyoruz. Kenelerin türleri çok önemli. Mesela Ixodes ricinus ise lyme hastalığını bulaştırabilir. Onu takibe alıyoruz. Kenenin ısırdığı yer kendiliğinden kapanıyorsa bir sorun yok. Eğer orada bir şişlik, kızarıklık olursa muhakkak hastaneye başvurulmalı. Lyme hastalığı, kenenin ısırmasıyla deriden bulaşan bakteriyel bir enfeksiyondur. Önce bir kızarıklık, sonra bir eritem gelişir o bölgede. Daha sonra ise nörolojik tutulmalara kadar giden, ciddi bir hastalık olduğunu söyleyebilirim" dedi.
SALGIN POPÜLASYONUN ARTMASINA NEDEN OLDU
Havaların ısınması ve salgın nedeniyle insanların doğadan uzak kalması nedeniyle kene popülasyonunun arttığını ifade eden Doç. Dr. Polat, “Keneler soğukkanlı hayvanlar olduğu için kış uykusuna yatarlar. Şu an havalar ısındı, 15 santigrat derecenin üzerinde aktiviteleri başlar. Şu an aktif durumdalar. Kenelerin de besin kaynağı, bulduğu omurgalı hayvanlardan kan emmek. İnsanlar da araziye çıktıkları için, birçok insanda şu an kene tutulması kadar doğal bir şey yok. İnsanlar koronavirüs dolayısıyla araziye çıkamadılar, sokağa çıkma kısıtlamaları da vardı. Kenelerin üreme alanları, popülasyonları daha da arttı. Üreme alanlarına kimse dokunmadığı için kenelerin rahatlıkla çoğalmaları oldu. Şu anda zaten kene vakaları başladı." dedi.
ÖLÜMLERE NEDEN OLMUYOR
İstanbul’daki kene vakalarının genellikle ölümlerle sonuçlanmamasının nedenini ise Polat, “Kırım Kongo Kanamalı Ateşi hastalığını bulaştıran Hyalomma marginatum’dur. Hyalomma İstanbul’da var ama bunlar Kırım Kongo Kanamalı Ateşinin etkenini taşımıyorlar. Yani İstanbul’da, Bolu’dan bu tarafa Kırım Kongo Kanamalı Ateşi hastalığı bildirilmemiştir ki, en hızlı ölüme neden olan hastalık da Kırım Kongo Kanamalı Ateşidir. Mesela İstanbul’da bizim yaptığımız çalışmalarda riketsiya enfeksiyonları var ki bunun kenelerde yüzde 25 taşıyıcılığı var. Lyme hastalığını da görebiliyoruz yüzde 2,5-3 oranında. Onu da özellikle ormanlık alanlarda Ixodes ricinus türü keneler bulaştırıyorlar" diye konuştu.
CİDDİ BİR HASTALIK OLAN “LYME" İSTANBUL’DA GÖRÜLEBİLİR
Kene türlerini bilmenin, neden olacağı hastalıkları tespit etmek noktasında önemini vurgulayan Polat, “Keneyi çıkardıktan sonra türlerine bakıyoruz. Kenelerin türleri çok önemli. Mesela Ixodes ricinus ise lyme hastalığını bulaştırabilir. Onu takibe alıyoruz. Kenenin ısırdığı yer kendiliğinden kapanıyorsa bir sorun yok. Eğer orada bir şişlik, kızarıklık olursa muhakkak hastaneye başvurulmalı. Lyme hastalığı, kenenin ısırmasıyla deriden bulaşan bakteriyel bir enfeksiyondur. Önce bir kızarıklık, sonra bir eritem gelişir o bölgede. Daha sonra ise nörolojik tutulmalara kadar giden, ciddi bir hastalık olduğunu söyleyebilirim. Kırım Kongoda ölüm bir haftada gerçekleşir, lymeda ise o nörolojik tutulmaların olması için 3-4 ay geçmesi gerekiyor. Daha uzun vadede etkili, insan hareketlerini kısıtlayan bir takım ciddi şeylere neden oluyor" dedi.
"VÜCUTTAN ÇIKARTILAN KENELER ÇÖPE ATILMAMALI"
Kene ısırmasıyla karşılaşan vatandaşların yapması gerekenlerle ilgili olarak ise Doç. Dr. Polat, şöyle devam etti:
“Vatandaşlarda kene varsa, en yakın sağlık ocağına gidip onu çıkarttırmalı. Kenesini atmamalı, getirdiklerinde biz onun tipine bakarız çünkü o bizi ilgilendiriyor. Ona göre biz hastayı yönlendiriyoruz. Şunu yapıyorlar, sağlık kuruluşunda keneyi çıkarıp çöpe atıyorlar. Sonra o bölgede enfeksiyon başlangıcı olduğunda, kenenin türünü bilmediğimiz için, ne olacağını kestirmek zor. Ama kenenin türüne bakınca, hangi enfeksiyonu bulaştıracağını biliyoruz. Her kene her hastalığına vektörlük yapmıyor. Bize gelen hastalarda biz şunu görüyoruz. Genellikle kene, ayaktan giriyor, tırmanıyor ya dizin arka tarafında ya da apış arasında oluyor. Araziye çıkarken çoraplarını pantolonlarının üzerine koyarlarsa bu bir yöntem. İlaç sıkmanın bir fonksiyonu yok. Ancak güçlü bir zehir sıkacaksın, o da doğru bir şey değil. Bir de kene kahverengidir, beyaz çorap giyinirseniz, rahatlıkla fark edebilirsiniz. Pikniklerden sonra da kendinizi kontrol etmeniz önemli. Bu sene popülasyon daha fazla olacak. Çünkü insanlar doğaya zarar veremediler. Geçmiş yıllara göre kenelerin artacağını söyleyebilirim."